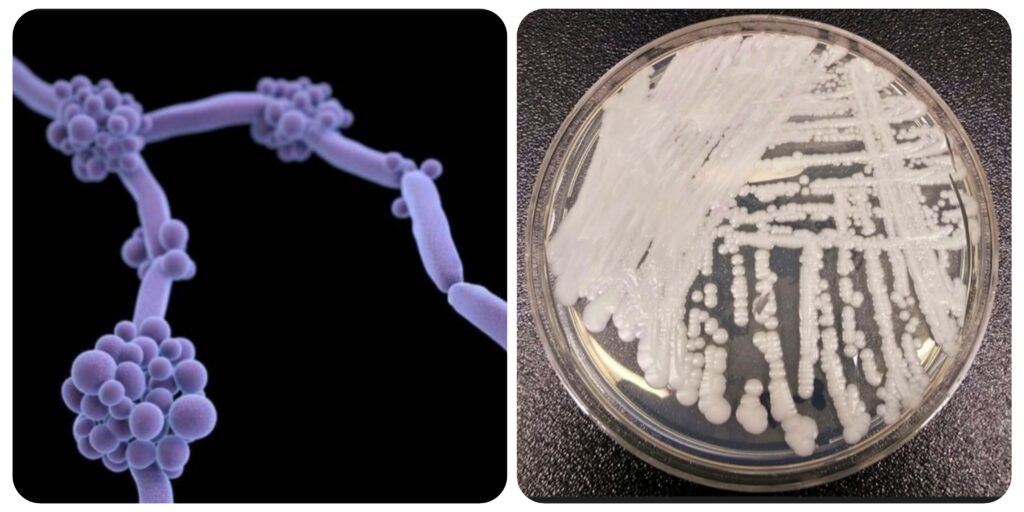
InCollage_20260104_085511051

The fungal species Candida auris is spreading across the globe: Warning
Published by RawNews1st
A review published in late December 2025 in Microbiology and Molecular Biology Reviews indicates that Candida auris (C. auris) is rapidly expanding globally with heightened virulence and multi-drug resistance. As of January 2026, the pathogen has been detected in at least 61 countries and is increasingly recognized as a regional endemic presence in the United States, appearing in at least 27 states.
It can cause deadly infections, especially in people with weakened immune systems, and spreads easily in healthcare settings like hospitals and nursing homes, causing outbreaks.

C auris is similar to the zombie-ant fungus at the heart of post-apocalyptic drama The Last of Us.
It was first spotted in 2009 in Japan in a sample from a patient’s ear – but it has since torn across the globe at an alarming rate.
The fungus was identified as a major public health threat in India in 2014.
More recently, high case numbers of C. auris have been causing alarm in the US.
It has infected at least 7,000 people across 27 states throughout 2025, according to data from the Centers for Disease Control and Prevention (CDC).
The bug is also increasingly being detected in hospitals in England – particularly in the years after travel restrictions imposed during the Covid-19 pandemic were lifted.
A report published by the UK Health Security Agency (UKHSA) earlier this year stated: “There have been significant healthcare associated outbreaks affecting NHS trusts in London and the South-East of England.





